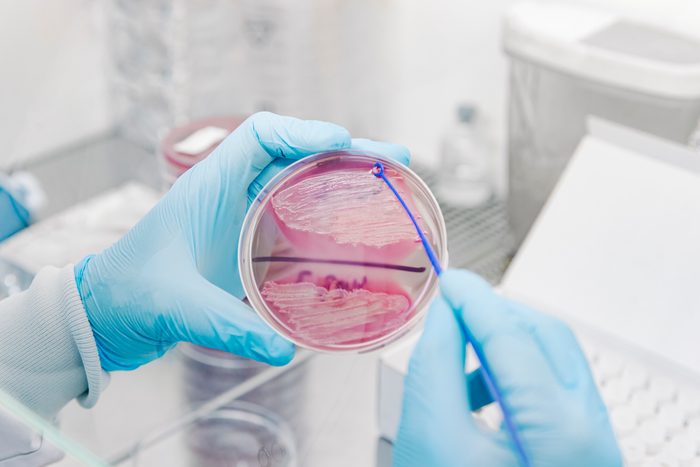
Worker scientist taking some colonies from a petri dish with a loop

Whether or not you study inside the toilet bowl, this anomaly can stand out. A doctor speaks to the common causes for oily pee, and when to seek medical attention.
If You See Oil in Your Urine, an Expert Doctor Explains What It Means

Normal urine color can vary, from clear to pale yellow. However, certain health issues can influence its appearance. For instance, there are times when your urine might contain white particles. In some cases, you might even notice it looks as though oil is separating out from the normal watery composition.
If you spy oil swirling in your urine, this can be linked to a shift in your diet or indicate a serious underlying condition, such as diabetes or nephrotic syndrome, which is a kidney-related illness.
Ahead, a doctor explains the causes of oily urine and offers guidance on when to seek medical advice.

Why do I have oily urine?
1. Lipiduria
The medical term for having fats or lipids in your urine is lipiduria, and it’s one of the main causes of oily urine. This often happens when kidney diseases damage the kidney’s filtration barrier, which is there to keep larger molecules like fats out of your urine. When this barrier is damaged, fats can leak into your urine, making it look oily.
A common cause of lipiduria is nephrotic syndrome, a kidney disorder that can be triggered by diabetes, lupus, or heart disease. Additional symptoms of nephrotic syndrome include swelling of the ankles and feet, weight gain, fatigue, foamy urine, and low protein levels in the blood.

2. Ketosis
If you’re on a ketogenic (keto) diet, you might notice oily urine. This happens because low-carb diets can make your body go into ketosis, where it burns fat for energy instead of carbohydrates.
While ketosis is normal for people on a keto diet, it can cause problems for those with diabetes. If you have diabetes and notice symptoms like high blood sugar, trouble breathing, extreme thirst, or confusion, call your doctor right away as this can lead to a life-threatening condition known as diabetic ketoacidosis.

3. Dehydration
Dehydration can cause your urine to appear oily due to it becoming highly concentrated with waste products as your body attempts to conserve water. However, it’s important to note that other symptoms of dehydration, such as dry mouth, dizziness, and thirst, typically manifest before changes in urine appearance.

4. Vitamins and supplements
Taking too many water-soluble vitamins, like B-complex and vitamin C, can change how your urine looks. When you take more of these vitamins than your body needs, it gets rid of the extra through your urine, which can make it appear oily. Talk to your doctor before trying new supplements or changing your supplement routine.
5. Chyluria
Chyluria is a condition that happens when your lymphatic fluid, which helps fight infections and keeps fluid levels balanced, gets mixed into urine. This can make urine look milky or oily.
Chyluria can be caused by parasitic infections, problems with the lymphatic system, or physical injuries. People who live in or travel to places where parasitic infections are common may be more likely to experience chyluria.

6. Urinary tract infections (UTIs)
UTIs don’t directly cause oily urine, but severe infections can sometimes create a layer on top of the urine that might look like oil. UTIs usually cause other symptoms, too, like pain or burning when you pee, needing to pee a lot, and fever.

When to see a doctor about oily urine
If you frequently observe oil in your urine, you must schedule a visit with your healthcare provider. This is especially important if you experience any of the following symptoms:
- Pain or burning when you pee
- Urine that looks an unusual color or is always cloudy
- Swelling in your legs, ankles, or feet
- High blood pressure
- Abdominal pain
- Rapid weight gain or weight loss
- Nausea or vomiting
- Foamy or frothy urine
- Persistent fatigue
- Fever
- Difficulty breathing
During your appointment, your doctor will order tests, including urinalysis and blood work, to identify the underlying cause of your oily urine and develop an appropriate treatment plan.
For more wellness updates, subscribe to The Healthy by Reader’s Digest newsletter and follow The Healthy on Facebook and Instagram. Keep reading:

















